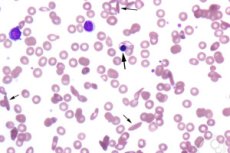

Medisinsk ekspert i artikkelen
Nye publikasjoner
Aplastisk krise: symptomer, diagnose, behandling og prognose
Sist oppdatert: 04.04.2026

Vi har strenge retningslinjer for kildekode og lenker kun til anerkjente medisinske nettsteder, akademiske forskningsinstitusjoner og, når det er mulig, medisinsk fagfellevurderte studier. Merk at tallene i parentes ([1], [2] osv.) er klikkbare lenker til disse studiene.
Hvis du mener at noe av innholdet vårt er unøyaktig, utdatert eller på annen måte tvilsomt, kan du velge det og trykke Ctrl + Enter.
En aplastisk krise er en akutt og vanligvis midlertidig opphør av produksjonen av røde blodlegemer i benmargen, noe som fører til at hemoglobinnivåene faller kraftig over flere dager. Oftest er dette ikke den klassiske aplastiske anemi med totalbenmargssuppresjon, men snarere en forbigående erytroid-suppresjon, som er spesielt farlig for personer med kronisk hemolyse, fordi deres røde blodlegemer allerede har en kortere levetid enn vanlig. [1]
I praksis er denne tilstanden oftest assosiert med parvovirus B19 -infeksjon. Hos friske individer er en slik infeksjon ofte mild eller asymptomatisk, men hos pasienter med sigdcelleanemi, talassemi, arvelig sfærocytose og andre hemolytiske anemier kan det samme viruset forårsake alvorlig, noen ganger livstruende, anemi.[2]
Det er viktig å umiddelbart skille aplastisk krise fra aplastisk anemi. I en krise er produksjonen av røde blodlegemer primært undertrykt, og prosessen er vanligvis reversibel, mens aplastisk anemi er en annen sykdom assosiert med mer dyptgående benmargsskade og ofte pancytopeni. For klinikeren er dette et grunnleggende skille, ettersom diagnosen, hvor raskt handlingen må gjøres og prognosen for disse tilstandene er forskjellige. [3]
| Nøkkelfunksjon | Aplastisk krise | Aplastisk anemi |
|---|---|---|
| Start | Akutt, i dager | Oftest subakutt eller kronisk |
| Hovedproblemet | En kraftig nedgang i produksjonen av røde blodlegemer | Global benmargssvikt |
| Den mest typiske utløseren | Parvovirus B19 | Autoimmune, medikamentelle, giftige og andre årsaker |
| Risikogruppe | Personer med kronisk hemolyse | Alle pasienter, avhengig av årsaken |
| Strømme | Vanligvis forbigående | Det kan være langt og alvorlig. |
| Grunnlaget for bistand | Støtte, transfusjon, noen ganger immunglobulin | Spesialisert behandling for beinmargssvikt |
Tabell satt sammen fra GeneReviews, gjennomgang av ren rødcelleaplasi og gjennomgang av aplastisk anemi. [4]
Kode i henhold til ICD-10 og ICD-11
I den internasjonale klassifiseringen av sykdommer, 10. revisjon, er den nærmeste uavhengige koden for forbigående aplastisk krise D60.1, forbigående ervervet ren rødcelleaplasi. Dette er viktig fordi begrepet «aplastisk krise» i klinisk praksis vanligvis beskriver midlertidig undertrykkelse av erytroidproduksjon, snarere enn hele gruppen av aplastiske anemier. [5]
Det er en praktisk nyanse med den internasjonale klassifiseringen av sykdommer, 11. revisjon: i åpne sekundære klassifiseringsressurser er den nærmeste kategorien 3A61, ervervet ren rødcelleaplasi, og den nærmeste ekvivalenten for den akutte varianten er 3A61.0, akutt ervervet ren rødcelleaplasi. Imidlertid krever faktisk koding ofte ytterligere spesifisering av den underliggende sykdommen, som sigdcelleanemi, og om nødvendig parvovirus B19-infeksjon, så den endelige kodingen avhenger av den kliniske konteksten og nasjonale koderegler. [6]
| System | Kode | Hva betyr det | Kommentar |
|---|---|---|---|
| ICD-10 | D60.1 | Forbigående ervervet rødcelleaplasi | Den nærmeste koden for aplastisk krise |
| ICD-10 | D57.0 og underoverskrifter | Sigdcelleanemi med krise | Ofte nødvendig som en kode for en underliggende sykdom |
| ICD-11 | 3A61 | Ervervet rødcelleaplasi | Gruppens neste seksjon |
| ICD-11 | 3A61.0 | Akutt ervervet rødcelleaplasi | Den nærmeste analogen til en forbigående krise |
| Ytterligere koding | Avhengig av situasjonen | Bakgrunnshemolytisk anemi og infeksjon | Avklarer det kliniske scenariet |
Tabellen er basert på den internasjonale klassifiseringen av sykdommer, 10. revisjon fra Verdens helseorganisasjon, og sekundære kryssreferanseressurser for den internasjonale klassifiseringen av sykdommer, 11. revisjon. [7]
Epidemiologi
Det finnes få presise globale estimater av aplastisk krise som en separat tilstand, ettersom det ikke er en uavhengig infeksjon, men en komplikasjon som oppstår hos mottakelige pasienter med parvovirus B19 og kronisk hemolyse. I tillegg, ifølge Centers for Disease Control and Prevention, finnes det ingen rutinemessig parvovirus B19-overvåking i USA, så mange estimater er basert på serologiske data, laboratorieaktivitetsdata og pasientkohorter fra spesialiserte sentre. [8]
Parvovirus B19 er i seg selv ekstremt vanlig. Ifølge Centers for Disease Control and Prevention oppdages beskyttende antistoffer hos omtrent 50 % av personer innen 20-årsalderen og hos omtrent 70 % innen 40-årsalderen. En gjennomgang fra 2024 indikerer også at innen 15-årsalderen har omtrent 50 % av personer tegn på tidligere infeksjon, og innen 70-årsalderen 80–100 %. Dette forklarer hvorfor de fleste voksne allerede er immune, og alvorlige kriser er konsentrert i risikogrupper snarere enn i den generelle befolkningen. [9]
I 2024 ble det observert en markant økning i parvovirus B19-aktivitet i USA. Ved et stort pediatrisk senter for sigdcelleanemi i Atlanta var forekomsten av parvovirusassosiert aplastisk krise 35,6 per 1000 pasientår i de første 9 månedene av 2024, 3,6 ganger den samlede raten fra 2010 til 2023. I den samme observasjonsserien var de vanligste symptomene smerte (78 %), feber (62 %), tretthet (31 %) og respiratoriske symptomer (26 %), og komplikasjoner inkluderte akutt brystsyndrom, miltsekvestrasjon og hjerneslag.[10]
Pasienter med sigdcelleanemi har spesielt høy risiko på grunn av den korte levetiden til røde blodceller. GeneReviews bemerker at røde blodceller ved sigdcelleanemi lever omtrent 7–12 dager, sammenlignet med 100–120 dager for normale individer, så selv en 8–10 dagers opphør av erytropoiesen blir raskt klinisk dramatisk. [11]
Hos barn med kronisk hemolytisk anemi er aplastisk krise fortsatt en av de klassiske alvorlige formene for parvovirusinfeksjon. En gjennomgang fra 2024 og materiale fra Centers for Disease Control and Prevention bekrefter at pasienter med sigdcelleanemi, talassemi og arvelig sfærocytose er spesielt sårbare, og økt virussirkulasjon i 2024–2025 har nok en gang økt relevansen av dette problemet. [12]
| Epidemiologisk faktum | Hva som er kjent |
|---|---|
| Rutinemessig overvåking for parvovirus B19 i USA | Fraværende |
| Beskyttende antistoffer innen 20 år | Omtrent 50 % |
| Beskyttende antistoffer innen 40 år | Omtrent 70 % |
| Toppen av positive tester hos barn i 2024 | Spesielt 6-11 år gamle |
| Forekomst av aplastisk krise i 2024 ved ett større senter for sigdcelleanemi | 35,6 per 1000 pasientår |
| Økning i frekvens sammenlignet med 2010–2023 | 3,6 ganger |
Tabellen er basert på materiale fra Centers for Disease Control and Prevention og 2024 MMWR. [13]
Årsaker
Hovedårsaken til aplastisk krise er parvovirus B19-infeksjon. Dette viruset har en affinitet for erytroide stamceller og kan nesten fullstendig stoppe produksjonen av nye røde blodlegemer i flere dager. For de fleste friske mennesker fører ikke dette til alvorlig anemi, men for en pasient med en iboende kort levetid for røde blodlegemer kan denne pausen være kritisk. [14]
Klassiske underliggende tilstander som predisponerer aplastisk krise for sykdom inkluderer sigdcelleanemi, talassemi, arvelig sfærocytose og andre kroniske hemolytiske anemier. Centers for Disease Control and Prevention klassifiserer eksplisitt pasienter med sigdcelleanemi, talassemi og arvelig sfærocytose som risikogrupper, og en gjennomgang fra 2024 bekrefter det samme kliniske bildet. [15]
Selv om parvovirus B19 er den primære årsaken, er det ikke den eneste mulige utløseren. GeneReviews og NCBI Bookshelf indikerer at forbigående rødcelleaplasi kan være assosiert med andre infeksjoner, inkludert Streptococcus pneumoniae, Salmonella og Epstein-Barr-virus, men disse variantene er betydelig mindre vanlige og endrer ikke det faktum at parvovirus B19 fortsatt er den ledende etiologiske agensen. [16]
Hos immunkompromitterte pasienter kan bildet være annerledes. Hos dem utvikler akutt, forbigående erytropoiesestans seg noen ganger til en mer langvarig eller tilbakevendende erytropoiese-aplasi, fordi kroppen ikke klarer å generere en fullverdig nøytraliserende humoral respons, og viruset vedvarer lenger. I en slik situasjon vurderer legen ikke bare en klassisk krise, men også kronisk virusassosiert erytropoiese-aplasi. [17]
| Forårsake | Hvor typisk er det? | Klinisk kommentar |
|---|---|---|
| Parvovirus B19 | Det mest typiske | Hovedårsaken til aplastisk krise |
| Sigdcelleanemi som bakgrunn | Veldig typisk | Den mest kjente høyrisikogruppen |
| Arvelig sfærocytose som bakgrunn | Typisk | Det er også høy risiko for alvorlig anemi. |
| Thalassemia som bakgrunn | Typisk | En alvorlig krise er mulig |
| Andre infeksjoner | Sjeldnere | Mulig, men ikke dominerende |
| Immunsvikt | Endrer flyten | Øker risikoen for langvarig rødcelleaplasi |
Tabellen er satt sammen fra GeneReviews, 2024-gjennomgangen og materiale fra Centers for Disease Control and Prevention. [18]
Risikofaktorer
Den viktigste risikofaktoren er kronisk hemolyse. Hvis røde blodceller har kort levetid og kroppen er tvunget til å produsere nye celler konstant og raskt, fører selv et kort avbrudd i benmargsfunksjonen raskt til et betydelig fall i hemoglobin. Dette er grunnen til at aplastisk krise er typisk for sigdcelleanemi, talassemi og arvelig sfærocytose. [19]
Den andre store risikofaktoren er mangel på immunitet mot parvovirus B19. Centers for Disease Control and Prevention (CDC) viser at seropositiviteten øker med alderen, noe som betyr at barn og ungdommer har større sannsynlighet for å møte viruset for første gang og derfor har større risiko for akutt infeksjon. Dette stemmer overens med data fra 2024, hvor topper i positive tester forekom blant alderen 6–11 år. [20]
Den tredje risikofaktoren er nærkontakt innen familien, skolen og sykehuset i perioder med aktiv viremi. Centers for Disease Control and Prevention (CDC) bemerker at pasienter med aplastisk krise er smittsomme selv før klinisk gjenkjenning og forblir smittsomme i minst en uke etter at symptomene har startet. Dette har betydelige praktiske implikasjoner for familier med flere individer med hemolytisk anemi. [21]
En egen risikogruppe inkluderer pasienter med immunsvikt, inkludert de som har fått organ- eller stamcelletransplantasjoner, de med kreft, de som er infisert med humant immunsviktvirus eller de som gjennomgår cellegiftbehandling. Hos disse pasientene presenterer parvovirusinfeksjon seg ofte atypisk, vedvarer lenger og kan forårsake ikke bare en forbigående krise, men også kronisk rødcelleaplasi. [22]
| Risikofaktor | Hvorfor er det viktig? |
|---|---|
| Kronisk hemolyse | Gjør selv et kort avbrudd i erytropoiesen farlig |
| Barndom og ungdomstid | Høyere sjanse for primær eksponering for viruset |
| Mangel på immunitet mot parvovirus B19 | Øker sannsynligheten for akutt infeksjon |
| Nærkontakt med en smittet person | Øker risikoen for overføring |
| Immunsvikt | Øker risikoen for langvarig progresjon |
| Å ha flere sårbare familiemedlemmer | Øker sannsynligheten for intrafamiliær alvorlig klyngesykdom |
Tabell basert på data fra Centers for Disease Control and Prevention, GeneReviews og en gjennomgang av ren rødcelleaplasi.[23]
Patogenese
Parvovirus B19 retter seg selektivt mot erytroide progenitorceller. Det bruker P-antigenet som reseptor for celleinntreden, hvoretter det skader sene erytroide progenitorceller og effektivt stenger ned erytropoiesen i flere dager. Et karakteristisk funn for morfologer er stans i modning på pronormoblastnivå. [24]
Hos en frisk person kan denne pausen knapt være merkbar fordi de røde blodcellene deres er langlivede. Ved sigdcelleanemi er imidlertid levetiden til røde blodceller omtrent 7–12 dager, så en stopp i produksjonen i 8–10 dager fører raskt til et fall i hemoglobin på omtrent 1 gram per desiliter per dag. Det er denne misforholdet mellom ødeleggelsen av gamle celler og mangelen på nye som gjør krisen farlig. [25]
På laboratorienivå er retikulocytopeni en viktig patogenetisk markør. Dette er spesielt viktig for en person med hemolytisk anemi, da de normalt sett skal ha en forhøyet retikulocyttrespons. Når retikulocyttene plutselig faller, betyr det at benmargen har sluttet å kompensere for det kroniske tapet av røde blodlegemer. [26]
Hos en immunkompetent pasient dannes det raskt nøytraliserende antistoffer etter en akutt infeksjon, og krisen forekommer vanligvis bare én gang i livet. Hos en immunkompromittert pasient kan den humorale responsen være utilstrekkelig, viruset vedvarer, og i stedet for en kort krise utvikles det en mer langvarig rødcelleaplasi, noen ganger med tilbakefall. [27]
| Stadium av patogenese | Hva skjer |
|---|---|
| Viruspenetrasjon | Parvovirus B19 infiserer kroppen |
| Tropisme til erytroide celler | Viruset binder seg til P-antigenet |
| Hemming av erytropoese | Modningen av erytroidceller hemmes kraftig |
| Retikulocytopeni | Benmargen slutter å produsere nye røde blodlegemer. |
| Raskt fall i hemoglobin | Spesielt uttalt ved kronisk hemolyse |
| Bedring | Etter dannelsen av en immunrespons, gjenopptas erytropoiesen vanligvis |
Tabell satt sammen fra GeneReviews og oversikten over ren rødcelleaplasi. [28]
Symptomer
Klinisk sett viser en aplastisk krise seg vanligvis med plutselig svakhet, blekhet, alvorlig tretthet, svimmelhet, hjertebank og kortpustethet under anstrengelse eller til og med i hvile. Disse symptomene gjenspeiler et raskt fall i hemoglobin snarere enn den langsomme progresjonen av kronisk anemi, slik at pasienten og familien ofte merker endringen innen 1–3 dager. [29]
Noen pasienter opplever et prodrom for virusinfeksjon: lavgradig feber, uvelhet, muskelsmerter og forkjølelsessymptomer. Ved klassisk aplastisk krise med kronisk hemolyse er hudutslettet ofte fraværende eller mildt, i motsetning til ved vanlig «femte sykdom» hos barn, hvor utslettet ofte er merkbart. [30]
Hos barn og ungdom med sigdcelleanemi kan krisen være ledsaget av smerter, feber og til og med akutt brystsyndrom. I en studie fra 2024 av barn med sigdcelleanemi var de vanligste symptomene smerter (78 %), feber (62 %), svakhet (31 %) og luftveissymptomer (26 %). Dette er viktig fordi krisen i praksis ikke alltid presenterer seg som «ren anemi» uten andre plager. [31]
Ved et kraftig fall i hemoglobin oppstår tegn på kardiovaskulær dekompensasjon: takykardi, alvorlig kortpustethet, presynkope og noen ganger hjertesvikt. Disse situasjonene krever ikke bare bekreftelse av diagnosen, men også umiddelbar korrigering av anemi og hemodynamisk overvåking. [32]
Hvis en pasient presenterer seg med forstørret milt og et høyt antall retikulocytter i stedet for retikulocytopeni, bør legen ikke lenger vurdere en aplastisk krise, men heller miltsekvestrasjon eller en annen årsak til akutt anemi. Derfor er symptomene i seg selv viktige, men de vurderes alltid i forbindelse med blodprøver. [33]
| Symptom | Hvor typisk er det? |
|---|---|
| Skarp svakhet | Veldig typisk |
| Blekhet | Veldig typisk |
| Hjerteslag | Ofte |
| Dyspné | Ofte med alvorlig anemi |
| Feber | Det er ikke uvanlig |
| Smerter hos pasienter med sigdcelleanemi | Det er ikke uvanlig |
| Retikulocytopeni i tester | Viktig laboratoriemarkør |
Tabellen er satt sammen fra GeneReviews, anmeldelser av parvovirus B19 og 2024 MMWR. [34]
Klassifisering, former og stadier
Det finnes ingen enkeltstående, universell klinisk klassifisering for aplastisk krise. I praksis bruker leger en arbeidsinndeling basert på årsak, underliggende sykdom og alvorlighetsgrad. Dette er mer ærlig og nyttig enn å lage kunstige stadier der det ikke finnes noen internasjonal standard. [35]
Parvovirus-assosiert aplastisk krise skilles oftest fra sjeldnere ikke-parvovirusvarianter. Avhengig av den underliggende sykdommen vurderes krisen separat hos pasienter med sigdcelleanemi, talassemi, arvelig sfærocytose, autoimmun hemolyse og andre tilstander med forkortet levetid for røde blodlegemer. Dette skillet er viktig fordi de kliniske risikoene og differensialdiagnosen er forskjellige i disse gruppene. [36]
Basert på krisens forløp er det praktisk å snakke om ukomplisert og komplisert. Den ukompliserte varianten er begrenset til anemi og retikulocytopeni; den kompliserte varianten er ledsaget av akutt brystsyndrom, miltsekvestrasjon, kardiovaskulær dekompensasjon, nevrologiske hendelser eller vedvarende virusinfeksjon hos en immunkompromittert pasient. [37]
Hvis vi bruker konseptet med stadier, kan vi i klinisk arbeid vanligvis skille mellom et infeksjonsprodrom, en fase med retikulocytopeni med et raskt fall i hemoglobin, deretter en fase med retikulocyttrestitusjon og en gradvis tilbakeføring til det opprinnelige hemoglobinnivået. Denne beskrivelsen er ikke en offisiell skala, men den gjenspeiler sykdommens naturlige forløp godt. [38]
| Tilnærming til klassifisering | Alternativer |
|---|---|
| På grunn av | Parvovirusassosiert, annen smittsom, sjeldne ikke-smittsom |
| Ved underliggende sykdom | Sigdcelleanemi, talassemi, arvelig sfærocytose, andre hemolytiske anemier |
| Etter immunstatus | Immunkompetent pasient, immunsviktpasient |
| Med strømmen | Ukomplisert, komplisert |
| Etter varighet | Forbigående, langvarig eller tilbakevendende immunsvikt |
| Etter klinisk fase | Prodrom, retikulocytopeni og et fall i hemoglobin, bedring |
Tabellen er basert på nåværende oversikter over parvovirus B19, GeneReviews og en oversikt over ren rødcelleaplasi. [39]
Komplikasjoner og konsekvenser
Hovedkomplikasjonen er alvorlig symptomatisk anemi. Det kan føre til takykardi, alvorlig dyspné, presynkope og hjertesvikt, spesielt hos barn og hos pasienter med allerede begrensede kompensasjonsreserver. Litteraturen understreker tydelig at en krise kan bli en livstruende tilstand. [40]
Hos pasienter med sigdcelleanemi kan en krise innebære mer enn bare et fall i hemoglobin. I en serie fra 2024 inkluderte komplikasjonene akutt brystsyndrom i 27 % av tilfellene, miltsekvestrasjon i 11 %, hjerneslag i 3,6 % og nefrotisk syndrom i 1,8 %. Selv om disse dataene er fra et enkelt, stort senter, viser de tydelig at aplastisk krise kan utløse en kaskade av alvorlige hendelser. [41]
Hos immunkompromitterte pasienter er utfallet kanskje ikke en kortvarig krise, men en vedvarende virusinfeksjon med kronisk rødcelleaplasi. I denne gruppen er risikoen for et langvarig forløp, gjentatte transfusjoner og behovet for intravenøs immunglobulin høyere enn hos immunkompetente pasienter. [42]
Graviditet i pasientens miljø må også vurderes. Mens en aplastisk krise hos mor i seg selv er én sak, er en gravid kvinnes eksponering for parvovirus B19 en annen: viruset kan overføres til fosteret og forårsake alvorlig føtal anemi, hydrops fetalis og abort. Dette er ikke en komplikasjon av krisen i seg selv, men en viktig konsekvens av et virusutbrudd i familien eller på avdelingen. [43]
| Komplikasjon | Hva betyr dette i praksis? |
|---|---|
| Alvorlig anemi | Hastevurdering er nødvendig, noen ganger transfusjon |
| Kardiovaskulær dekompensasjon | Risiko for hjertesvikt og hypoksi |
| Akutt brystsyndrom | Spesielt viktig for sigdcelleanemi |
| Miltsekvestrering | Krever umiddelbar differensialdiagnose |
| Slag | En sjelden, men ekstremt alvorlig komplikasjon |
| Kronisk rødcelleaplasi | Mulig ved immunsvikt |
Tabell basert på MMWR 2024, GeneReviews og gjennomgang av ren rødcelleaplasi.[44]
Når du skal oppsøke lege
Hvis en person med sigdcelleanemi, talassemi, arvelig sfærocytose eller annen hemolytisk anemi plutselig utvikler alvorlig svakhet, ekstrem blekhet, takykardi, kortpustethet, svimmelhet, besvimelse, feber eller en uvanlig rask forverring av helsen, må man umiddelbart søke hjelp. I denne risikogruppen kan selv noen få dagers venting være for lang. [45]
Umiddelbar behandling er spesielt viktig hvis det er brystsmerter, rask pust, fall i oksygenmetning, forstørret milt, sterke smerter, nevrologiske symptomer, eller hvis pasienten er gravid eller har hatt nær kontakt med en gravid kvinne. I disse tilfellene vurderer legen ikke bare anemi, men også komplikasjoner av infeksjon eller en annen alvorlig årsak til akutt anemi. [46]
| Situasjon | Hastverk |
|---|---|
| Plutselig alvorlig svakhet og blekhet hos en pasient med hemolytisk anemi | Øyeblikkelig |
| Kortpustethet, takykardi, presynkope | Øyeblikkelig |
| Feber med et raskt fall i hemoglobin | Øyeblikkelig |
| Brystsmerter eller tegn på akutt brystsyndrom | Haster |
| Forstørret milt | Haster for å unngå sekvestrering |
| Kontakt av en gravid kvinne med sannsynlig parvovirus B19 | Hastekonsultasjon |
Tabell satt sammen fra GeneReviews, CDC og litteratur om miltsekvestrering. [47]
Diagnostikk
Diagnosen starter vanligvis med en enkel, men svært informativ kombinasjon: et plutselig fall i hemoglobin hos en pasient med kronisk hemolyse, kombinert med et lavt antall retikulocytter. Det er retikulocytopenien som gjør krisen så gjenkjennelig. For en pasient med hemolytisk anemi er dette et uvanlig funn, ettersom benmargen normalt er overbelastet og retikulocyttene bør være høye. [48]
Det første trinnet er en fullstendig blodtelling (CBC) med retikulocytter, vurdering av baseline og nåværende hemoglobin, og blodtype- og kompatibilitetstesting hvis sannsynligheten for transfusjon er høy. En gjennomgang av ren rødcelleaplasi viser at lavt hemoglobin og et markant redusert retikulocyttall med ofte normale hvite blodlegemer og blodplater sterkt støtter diagnosen, selv om samtidig cytopeni er mulig hos noen pasienter. [49]
Det andre trinnet er å bekrefte parvoviral opprinnelse. Hos immunkompetente pasienter brukes ofte serologi for immunglobuliner M og G, mens hos immunkompromitterte pasienter og i uklare tilfeller er polymerasekjedereaksjon for viralt DNA i blodet spesielt nyttig. En moderne oversikt fra 2025 understreker at diagnosen bekreftes ved å påvise viralt DNA i serum, benmarg eller annet vev, og kombinasjonen av immunglobuliner M og G bidrar til å skille mellom nylig og tidligere infeksjon. [50]
Det tredje trinnet er å evaluere komplikasjoner og alternative årsaker til akutt anemi. Hvis det er kortpustethet, brystsmerter eller redusert oksygenmetning, søker legen etter akutt brystsyndrom; hvis milten er forstørret, må sekvestrering utelukkes raskt; hvis nevrologiske symptomer er tilstede, må risikoen for hjerneslag vurderes. På dette tidspunktet kan røntgen av brystet, ultralyd av milten, kardiorespiratorisk overvåking og andre metoder være nødvendige, men de er ikke nødvendige for å bekrefte selve krisen, men for å søke etter dens komplikasjoner og etterligninger. [51]
En benmargsaspirasjon er ikke nødvendig for alle. Det vurderes hvis det kliniske bildet er atypisk, diagnosen forblir uklar, en annen benmargspatologi mistenkes, eller serologien er usikker. Morfologisk kan karakteristiske gigantiske pronormoblaster oppdages, men selv dette klassiske funnet bør ikke være det eneste grunnlaget for diagnose uten klinisk og laboratoriemessig sammenligning. [52]
Den trinnvise diagnostiske logikken er som følger: gjenkjenn akutt anemi, bekreft retikulocytopeni, vurder alvorlighetsgraden og behovet for transfusjon, sjekk for parvovirusinfeksjon, og utelukk deretter sekvestrering, hyperhemolyse, aplastisk anemi og andre årsaker. Denne sekvensen muliggjør oftest en rask diagnose uten unødvendige invasive prosedyrer. [53]
| Diagnostisk trinn | Hva gir det en lege? |
|---|---|
| Fullstendig blodtelling | Bekrefter anemi |
| Antall retikulocytter | Avslører viktig retikulocytopeni |
| Blodtype og kompatibilitet | Forbereder seg på en mulig transfusjon |
| Serologi for parvovirus B19 | Hjelper med å bekrefte nylig infeksjon |
| Polymerasekjedereaksjon for viruset | Spesielt nyttig ved immunsvikt og kontroversiell serologi |
| Evaluering av komplikasjoner og etterligninger | Hjelper med å oppdage sekvestrering, akutt brystsyndrom og hjerneslag |
Tabellen er basert på GeneReviews-gjennomgangen fra 2024, Pure Red Cell Aplasia-gjennomgangen og data fra Centers for Disease Control and Prevention.[54]
Differensialdiagnose
Den viktigste differensialdiagnosen er mellom aplastisk krise og miltsekvestrasjon. Begge tilstandene kan forårsake plutselig, alvorlig anemi, men sekvestrasjon har vanligvis en forstørret milt og et normalt eller forhøyet retikulocyttall, mens aplastisk krise har lavt retikulocyttall og ofte ingen åpenbar splenomegali. Denne laboratorie-kliniske kontrasten bidrar til å raskt skille mellom disse to farlige tilstandene. [55]
Den andre viktige oppgaven er å skille en krise fra en hemolytisk eller hyperhemolytisk episode. Ved økt hemolyse reagerer benmargen vanligvis med en økning i retikulocytter, og laboratorietegn på ødeleggelse av røde blodlegemer er mer uttalte. Ved en aplastisk krise er ikke hovedproblemet akselerert ødeleggelse, men den plutselige opphør av produksjon av nye røde blodlegemer. [56]
Den tredje gruppen av etterligninger inkluderer klassisk aplastisk anemi, andre former for ren rødcelleaplasi, medikamentindusert benmargssuppresjon, ondartede blodsykdommer og akutte infeksjoner med flere cytopenier. Her veiledes legen ikke av én enkelt test, men av hele bildet: varigheten av symptomene, involvering av andre cellelinjer, smeardata, virale tester og, om nødvendig, en benmargsundersøkelse. [57]
Hos en voksen pasient med atypisk presentasjon er det viktig å vurdere andre patologier: akutt blodtap, mekanisk hemolyse, autoimmun hemolytisk anemi, postoperative tilstander og vedvarende parvovirusinfeksjon hos immunkompromitterte pasienter. Derfor er diagnosen aplastisk krise ikke basert på et lavt hemoglobinnivå alene, men på en karakteristisk kombinasjon av sykehistorie, retikulocytopeni og bekreftelse av den underliggende årsaken. [58]
| Tilstand | Hva skiller det fra en aplastisk krise? |
|---|---|
| Miltsekvestrering | Forstørret milt og høy retikulocytrespons |
| Hemolytisk krise | Økt hemolyse og vanligvis høy retikulocytrespons |
| Aplastisk anemi | Mer utbredt benmargsinvolvering, ofte pancytopeni |
| Kronisk rødcelleaplasi | Lengre varighet, ofte immunsvikt |
| Akutt blodtap | Det er en kilde til blodtap, retikulocytter øker senere |
| Medikamentindusert benmargssuppresjon | Legemiddelrelaterte og ofte bredere cytopenier |
Tabellen er basert på GeneReviews, en gjennomgang av ren rødcelleaplasi, og materiale om miltsekvestrering. [59]
Behandling
Behandlingen starter med å vurdere alvorlighetsgraden av tilstanden i stedet for å vente på alle testresultater. Hvis pasienten fremstår blek, sløv, takykardisk, klager over kortpustethet eller er nær synkope, behandler legen pasienten som om vedkommende har potensielt livstruende anemi: ved å overvåke, gi venøs tilgang, hemodynamisk kontroll og ta blodprøver umiddelbart. Denne tilnærmingen er spesielt viktig hos barn med sigdcelleanemi og andre pasienter med kronisk hemolyse. [60]
Hovedbehandlingen er i de fleste tilfeller støttende behandling og rettidig transfusjon av røde blodlegemer. GeneReviews sier eksplisitt at det ved aplastisk krise er nødvendig med overvåking av hematokrit, retikulocytter og kardiovaskulær status, og blodtransfusjon kan være nødvendig. Målet er ikke nødvendigvis å "normalisere" hemoglobin til den ideelle verdien, men å trygt bringe pasienten ut av kritisk anemi. [61]
Hos immunkompetente pasienter forsvinner parvovirus-aplastisk krise oftest spontant etter dannelse av en humoral respons. Derfor, etter stabilisering av tilstanden og om nødvendig transfusjon, forblir behandlingen ofte støttende. Det er denne forbigående naturen som skiller krisen fra kroniske former for rødcelleaplasi. [62]
Hvis retikulocyttene ikke gjenopprettes og virusmengden vedvarer, vurderer legen intravenøs immunglobulin. GeneReviews bemerker at hvis retikulocyttresponsen ikke gjenopprettes, kan intravenøs gammaglobulin vurderes for å lette viruseliminering. Dette er spesielt relevant hos immunkompromitterte pasienter, hvis naturlige humorale respons er utilstrekkelig. [63]
Ved immunsvikt strekker behandlingen seg ofte utover bare transfusjon. Oversikter over parvovirusassosiert rødcelleaplasi understreker rollen til intravenøs immunglobulin som den primære etiotropiske støttende behandlingen, og i noen situasjoner er det nødvendig å samtidig justere immunsuppresjon, revidere antitumorbehandling eller søke en måte å gjenopprette immunresponsen på. Dette er ikke lenger en typisk kortvarig krise, men et mer komplekst klinisk scenario. [64]
Hvis det utvikler seg en krise hos en pasient med sigdcelleanemi og samtidig akutt brystsyndrom, nevrologiske symptomer eller en annen alvorlig vaskulær hendelse oppstår, behandles ikke bare anemi, men også den underliggende komplikasjonen. I slike tilfeller kan behandlingen omfatte oksygen, mer intensiv overvåking, antibiotika ved mistanke om infeksjon og skreddersydde transfusjonsbeslutninger basert på det komplette kliniske bildet. [65]
Infeksjonskontroll er også viktig. Centers for Disease Control and Prevention (CDC) bemerker at pasienter med aplastisk krise er smittsomme før symptomene oppstår og i minst en uke etter. På sykehuset krever dette isolasjon, og i familien krever det overvåking av søsken og andre nære kontakter med hemolytisk anemi. [66]
Det finnes for øyeblikket ingen nye standard antivirale legemidler mot parvovirus B19. Det finnes heller ingen godkjent vaksine som kan forhindre slike kriser. Nyheten ved moderne taktikker skyldes først og fremst ikke tilgjengeligheten av en ferdiglaget etiotropisk pille, men tidligere gjenkjenning av infeksjonen, utvidet molekylær diagnostikk, forbedret transfusjonsstøtte og utvikling av vaksinekandidater som ennå ikke er godkjent. [67]
For selve aplastisk krise er ikke benmargstransplantasjon eller genterapi standard førstelinjebehandling. For utvalgte pasienter med alvorlig sigdcelleanemi kan imidlertid slike behandlinger forbedre den langsiktige risikoen for tilbakevendende alvorlige hematologiske komplikasjoner fordi de adresserer den underliggende sykdommen. Dette er ikke en behandling for den umiddelbare krisen, men snarere for den underliggende årsaken som gjør krisen farlig. [68]
Praktisk behandling for aplastisk krise kan oppsummeres som følger: rask gjenkjenning, vurdering av alvorlighetsgrad, bekreftelse av retikulocytopeni, forberedelse av transfusjon, overvåking av kardiovaskulær status, bekreftelse eller utelukkelse av parvovirus B19, administrering av intravenøst immunoglobulin om nødvendig, og overvåking av komplikasjoner, spesielt hos pasienter med sigdcelleanemi. Denne tilnærmingen er for tiden best støttet av klinisk litteratur. [69]
| Behandlingsmetode | Når brukes det? |
|---|---|
| Observasjon og overvåking | Alle pasienter etter mistanke om krise |
| Transfusjon av røde blodlegemer | For alvorlig eller symptomatisk anemi |
| Oksygen- og hemodynamisk støtte | Ved hypoksi og dekompensasjon |
| Intravenøs immunglobulin | I fravær av retikulocyttgjenoppretting, immunsvikt, vedvarende infeksjon |
| Behandling av komplikasjoner | Ved akutt brystsyndrom, nevrologiske hendelser, sekvestrering |
| Isolasjonstiltak og smittesporing | Ved bekreftet eller sannsynlig parvovirusinfeksjon |
Tabell satt sammen fra GeneReviews, Centers for Disease Control and Prevention-materialer og oversikter over ren rødcelleaplasi.[70]
Forebygging
Per april 2026 finnes det ingen spesifikk godkjent vaksine mot parvovirus B19. Derfor er forebygging av aplastisk krise ikke basert på vaksinasjon, men på å redusere risikoen for infeksjon, tidlig gjenkjenning av infeksjon og god kontroll av underliggende hemolytisk sykdom. [71]
I perioder med økt virussirkulasjon er rutinemessige tiltak for å forebygge luftveisinfeksjoner spesielt viktige: håndhygiene, minimering av nærkontakt med synlig syke personer, overholdelse av smitteverntiltak på sykehus og årvåkenhet i familier med barn med sigdcelleanemi eller arvelig sfærocytose. I 2024–2025 oppfordret Centers for Disease Control and Prevention spesifikt helsepersonell til å fremheve den økte aktiviteten til parvovirus B19 og behovet for å overvåke høyrisikogrupper. [72]
For pasienter med kronisk hemolytisk anemi inkluderer praktisk forebygging også å kjenne til baseline-hemoglobinnivået, regelmessig overvåking, rask tilgang til en hematolog og en klar familieplan for plutselig blekhet, svakhet eller feber. Dette forhindrer ikke infeksjon fullstendig, men det reduserer tiden til diagnose og behandling, som ofte er den avgjørende faktoren for utfallet. [73]
| Forebyggende tiltak | Praktisk betydning |
|---|---|
| Det finnes ingen godkjent vaksine. | Det er umulig å stole på spesifikk immunprofylakse |
| Håndhygiene og forholdsregler for åndedrett | Reduserer risikoen for virusoverføring |
| Rask gjenkjenning av symptomer | Reduserer behandlingsforsinkelser |
| Observasjon av en hematolog | Hjelper deg å forstå utgangspunktet ditt og en handlingsplan |
| Overvåking av familiekontakter | Viktig hos flere sårbare pasienter |
| Informer gravide kontakter | Reduserer risikoen for å gå glipp av obstetriske komplikasjoner ved infeksjon |
Tabellen er basert på materiale fra Centers for Disease Control and Prevention og gjennomganger av vaksinestrategier mot parvovirus B19.[74]
Prognose
De fleste immunkompetente pasienter har en god prognose hvis krisen oppdages raskt og alvorlig anemi korrigeres. Når kroppen genererer en humoral respons, gjenopprettes erytropoiesen vanligvis, og tidligere infeksjoner gir vanligvis livslang immunitet. [75]
Prognosen forverres hvis diagnosen stilles forsinket, hvis hemoglobinnivået faller for raskt, hvis krisen kompliseres av akutt brystsyndrom, miltsekvestrasjon eller en nevrologisk hendelse, og hvis pasienten har nedsatt immunforsvar. I slike situasjoner øker behovet for gjentatte transfusjoner, intravenøs immunglobulin og langtidsobservasjon. [76]
For pasienter med kronisk hemolytisk anemi er aplastisk krise vanligvis en sjelden hendelse, men det er nettopp derfor den er farlig: familien gjenkjenner den kanskje ikke umiddelbart ut fra symptomene. Tre faktorer bestemmer det langsiktige resultatet: rask behandling, nøyaktig differensialdiagnose og kontroll av den underliggende sykdommen. [77]
| Prognosefaktor | Innflytelse |
|---|---|
| Rask gjenkjenning | Forbedrer resultatet |
| Rettidig transfusjon | Reduserer risikoen for dekompensasjon |
| Immunkompetanse | Fremmer vanligvis full bedring |
| Immunsvikt | Øker risikoen for langvarig progresjon |
| Komplikasjoner av sigdcelleanemi | Forverre prognosen |
| Forsinket diagnose | Øker risikoen for alvorlig hypoksi og komplikasjoner |
Tabell satt sammen fra GeneReviews, Centers for Disease Control and Prevention-materialer og oversikter over ren rødcelleaplasi.[78]
Vanlige spørsmål
Er aplastisk krise og aplastisk anemi det samme?
Nei. Aplastisk krise er vanligvis en midlertidig opphør av produksjonen av røde blodlegemer, oftest på grunn av parvovirus B19 og kronisk hemolyse. Aplastisk anemi er en annen sykdom assosiert med mer utbredt benmargssvikt. [79]
Hvorfor er en krise spesielt farlig ved sigdcelleanemi?
Fordi ved sigdcelleanemi lever røde blodceller i omtrent 7–12 dager, i stedet for de normale 100–120 dagene. Derfor forårsaker selv et kort avbrudd i erytropoiesen raskt alvorlig anemi. [80]
Hva er de viktigste testene?
De viktigste er en fullstendig blodtelling, retikulocytter og tester for parvovirus B19. Retikulocytopeni er nøkkelen til diagnose, og bekreftelse av årsaken gjøres ofte ved serologi eller polymerasekjedereaksjon. [81]
Trenger alle en benmargsaspirasjon?
Nei. Det er bare nødvendig hvis funnene er atypiske eller diagnosen er tvilsom. I de fleste typiske tilfeller stilles diagnosen basert på en kombinasjon av kliniske symptomer, retikulocytopeni og bekreftelse av parvovirusinfeksjon. [82]
Er blodoverføring alltid nødvendig?
Ikke alltid, men svært ofte i tilfeller av alvorlig symptomatisk anemi. Avgjørelsen avhenger av alvorlighetsgraden av symptomene, hvor dypt hemoglobinfallet er og kardiovaskulær toleranse. [83]
Er det mulig å få aplastisk krise igjen?
Hos immunkompetente pasienter er dette vanligvis usannsynlig fordi en vedvarende immunrespons utvikles etter parvovirusinfeksjon. Hos immunkompromitterte pasienter er imidlertid et mer langvarig eller tilbakevendende forløp mulig. [84]

Viktige poeng fra eksperter
Marilyn A. Bender, MD, PhD, Institutt for pediatri ved University of Washington, er forfatter av GeneReviews om sigdcelleanemi.
Hennes hovedtese i praksis er svært klar: aplastisk krise er en midlertidig avbrudd i produksjonen av røde blodlegemer, vanligvis assosiert med parvovirus B19, og ved sigdcelleanemi kan den raskt bli livstruende på grunn av den korte levetiden til røde blodlegemer. Derfor følger den riktige kliniske logikken: vurder umiddelbart hemoglobin, retikulocytter og kardiovaskulær status, i stedet for å vente på at tilstanden skal «selvbestemme». [85]
Katie Carlberg, MD, Institutt for pediatri, University of Washington, medforfatter av GeneReviews om sigdcelleanemi.
De praktiske anbefalingene i denne gjennomgangen antyder at krisehåndtering vanligvis dreier seg om overvåking, transfusjon om nødvendig, og venting på at retikulocyttene bedring. Hvis retikulocyttresponsen ikke kommer tilbake, bør intravenøs immunoglobulin og mulig vedvarende virusinfeksjon vurderes. [86]
Russell E. Ware, MD, PhD, direktør for avdelingen for hematologi ved Cincinnati Children's Hospital Medical Center, professor i pediatri og ekspert på sigdcelleanemi.
Hans kliniske arbeid og forskningsprofil fremhever hva som er spesielt viktig for temaet aplastisk krise: hos barn med sigdcelleanemi kan ikke alvorlige hematologiske komplikasjoner vurderes isolert. Ethvert plutselig fall i hemoglobin må vurderes i sammenheng med hele sykdommen, med rask søken etter komplikasjoner og tidlig transfusjonsberedskap. [87]

